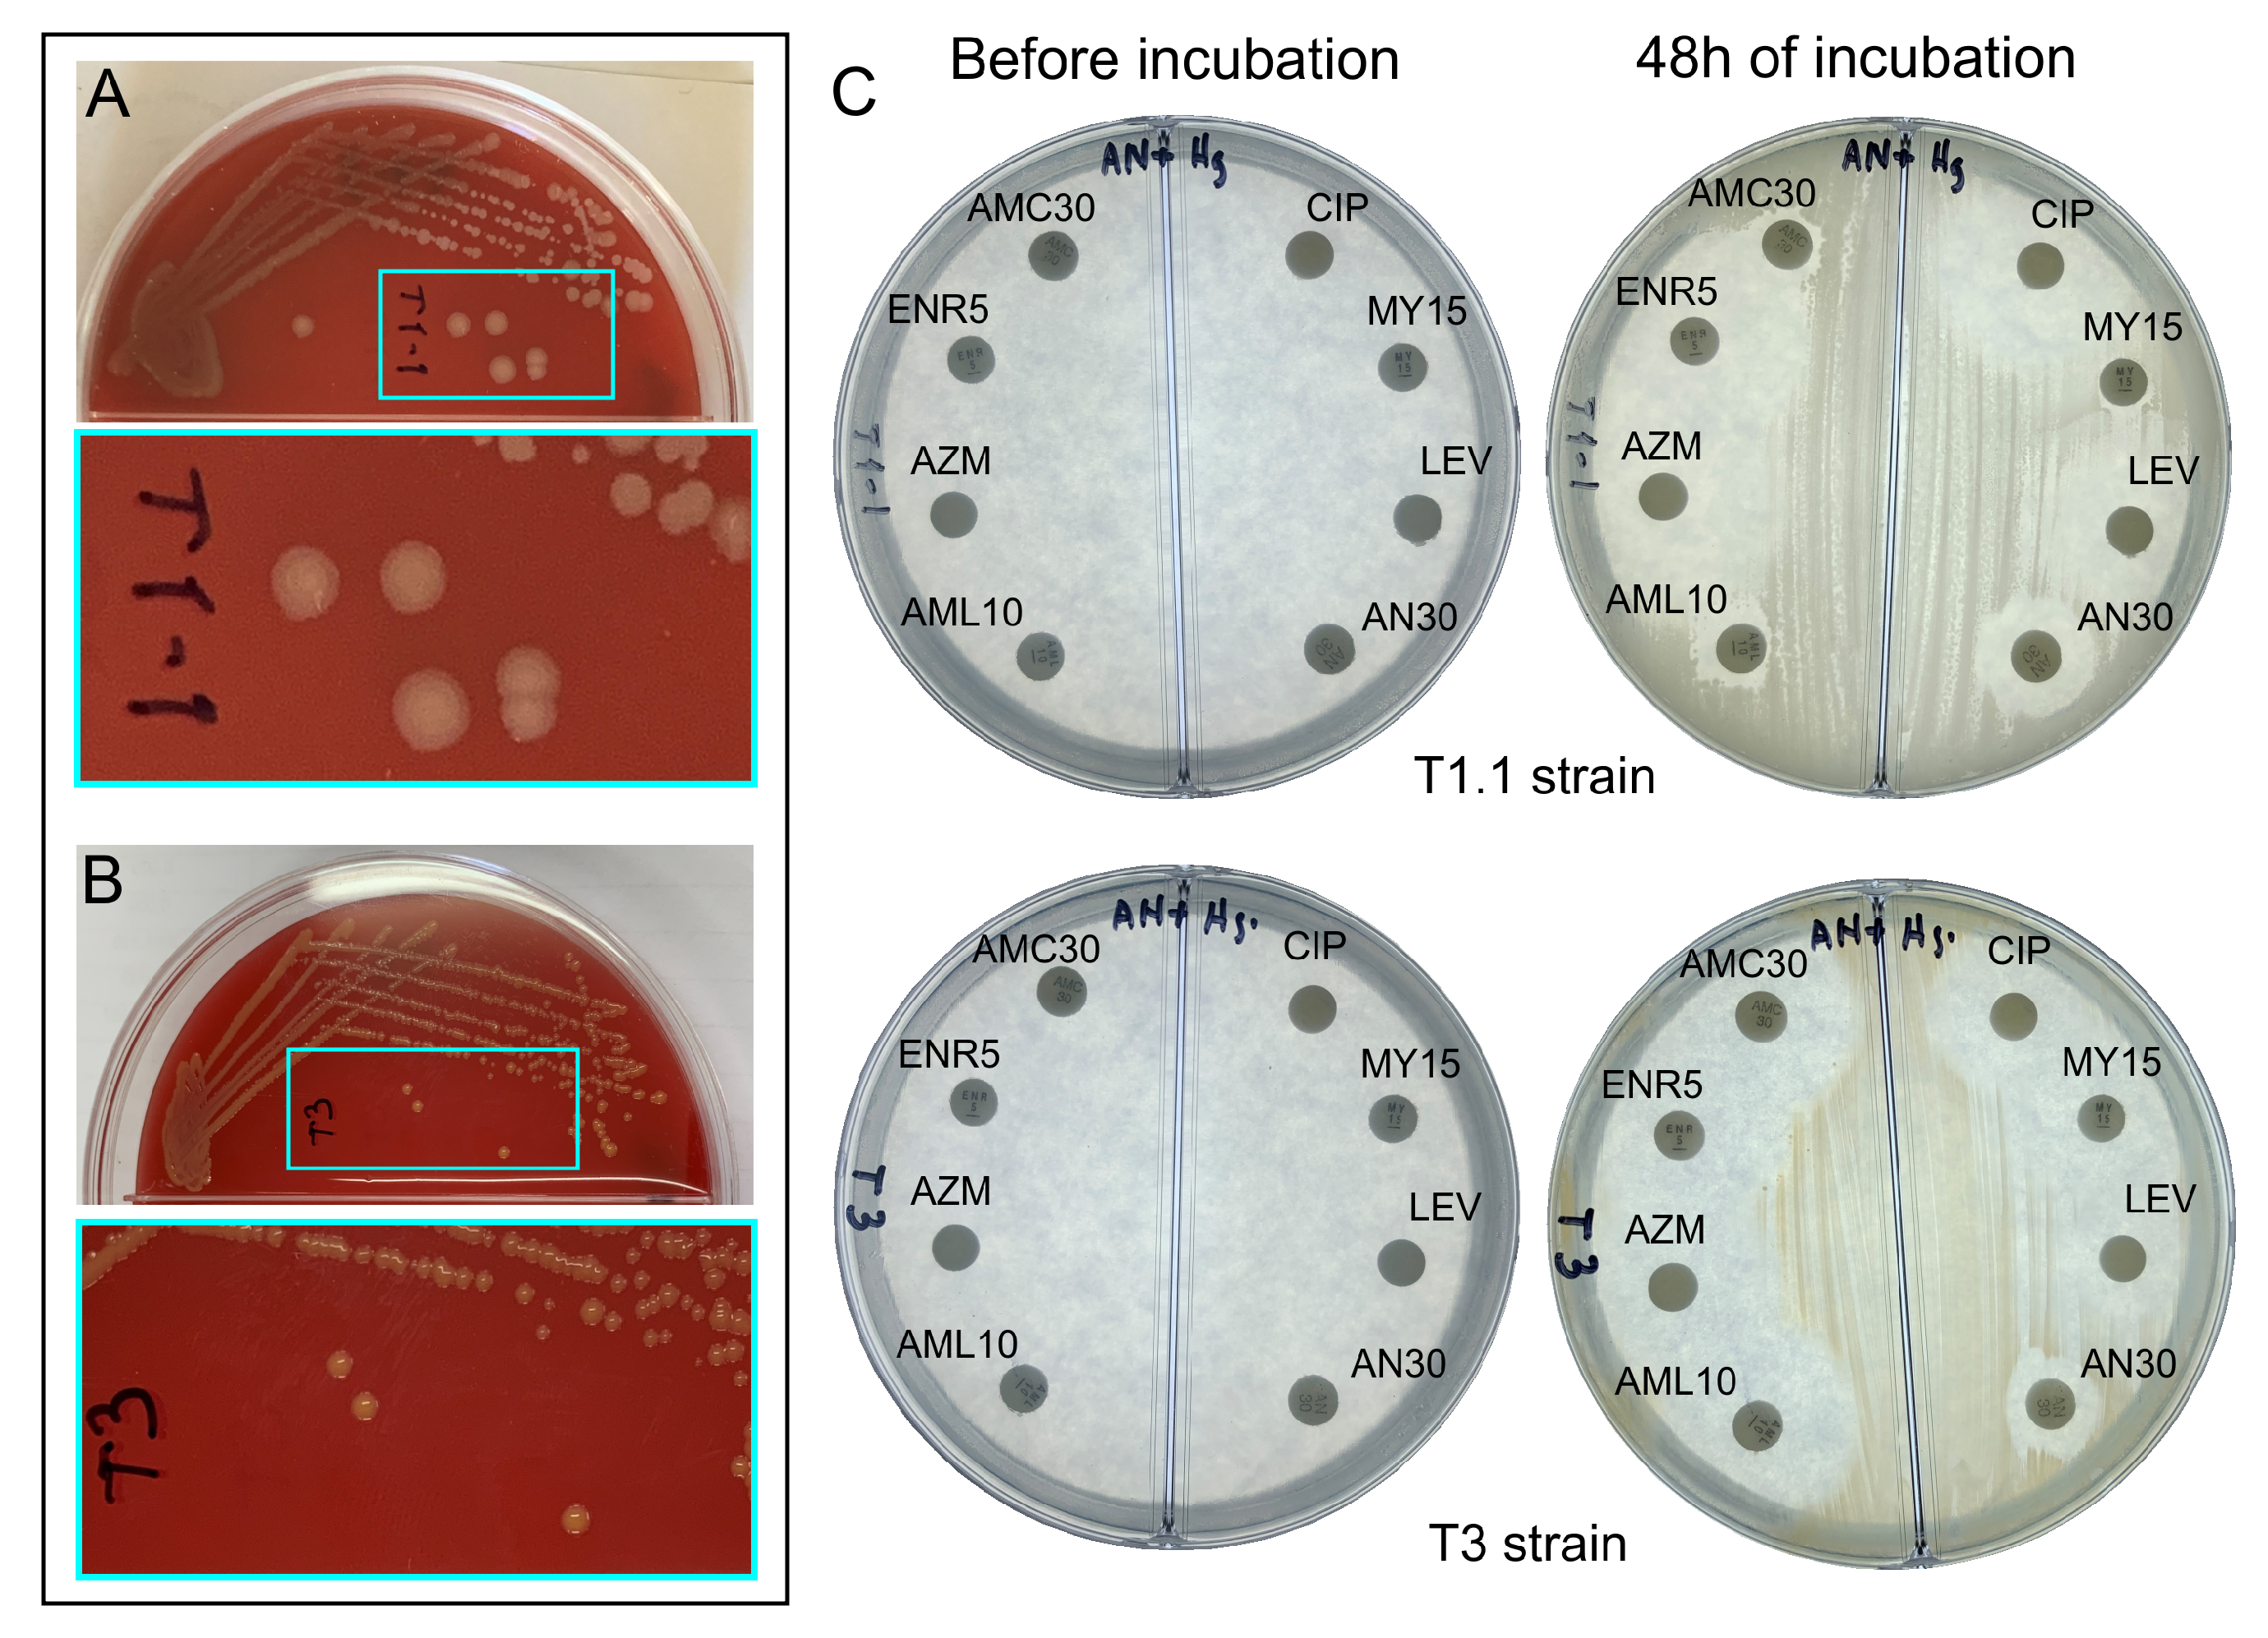
Sustainability 14 10272 g003 Sustainability 14 10272 g003

Peruvian Native Bacterial Strains as Potential Bioremediation Agents in Hg-Polluted Soils by Artisanal Mining Activities in Southern Peru
Abstract
1. Introduction
2. Materials and Methods
2.1. Study Area
2.2. Sampling and Isolation of Native Bacterial Strains
2.3. Purification
2.4. DNA Extraction, Sequencing, and Molecular Identification of the Resistant Bacteria
2.5. Morphological Characterization and Antibiograms
2.6. Hg Removal Capacity of T1.1 and T3 Strains
2.7. Kinetic Modeling
2.8. Statistical Analysis
3. Results and Discussion
3.1. Culture, Isolation, and Identification of Bacterial Strains
3.1.1. T1.1 Strain
3.1.2. T3 Strain
3.2. Morphological Characterization and Antibiograms of T1.1 and T3 Strains
3.2.1. T1.1 Strain
3.2.2. T3 Strain
3.3. Hg Removal by the T1.1 and T3 Strains
3.4. Kinetics Studies of Hg Removal
3.5. Study Limitations
4. Conclusions
Author Contributions
Funding
Institutional Review Board Statement
Informed Consent Statement
Data Availability Statement
Acknowledgments
Conflicts of Interest
References
- MINAM. Anuario Minero 2021; Ministerio del Ambiente (Ministry of Environment): Lima, Peru, 2021.
- Aranoglu, F.; Flamand, T.; Duzgun, S. Analysis of Artisanal and Small-Scale Gold Mining in Peru under Climate Impacts Using System Dynamics Modeling. Sustainability 2022, 14, 7390. [Google Scholar] [CrossRef]
- La Minería Informal se Extiende por la Amazonía sin Control ni Cifras Oficiales. Available online: https://ojo-publico.com/3529/la-mineria-informal-se-extiende-por-la-amazonia-sin-control (accessed on 11 July 2022).
- Veiga, M.M.; Maxson, P.A.; Hylander, L.D. Origin and consumption of mercury in small-scale gold mining. J. Clean. Prod. 2006, 14, 436–447. [Google Scholar] [CrossRef]
- Tabelin, C.B.; Silwamba, M.; Paglinawan, F.C.; Mondejar, A.J.S.; Duc, H.G.; Resabal, V.J.; Opiso, E.M.; Igarashi, T.; Tomiyama, S.; Ito, M.; et al. Solid-phase partitioning and release-retention mechanisms of copper, lead, zinc and arsenic in soils impacted by artisanal and small-scale gold mining (ASGM) activities. Chemosphere 2020, 260, 127574. [Google Scholar] [CrossRef] [PubMed]
- La Minería Informal se Extiende por la Amazonía sin Control ni Cifras Oficiales. Available online: https://www.pureearth.org/the-toxic-toll-of-mercury-facts-figures-and-the-future-of-dancing-cat-fever-disease/ (accessed on 18 July 2022).
- Zolnikov, T.R.; Ortiz, D.R. A systematic review on the management and treatment of mercury in artisanal gold mining. Sci. Total Environ. 2018, 633, 816–824. [Google Scholar] [CrossRef]
- Cuzcano, V.T. Minería ilegal e informal en el Perú: Impacto socioeconómico; Sonimágenes del Perú SCRL: Lima, Peru, 2015; Cuadernos 21 de CooperAcción 2; Available online: https://cooperaccion.org.pe/publicaciones/mineria-ilegal-e-informal-en-el-peru-impacto-socioeconomico-2/ (accessed on 20 April 2022).
- Wiener, L. La gobernanza de la minería en pequeña escala en el Perú; Sonimágenes del Perú SCRL: Lima, Peru, 2019; Available online: https://cooperaccion.org.pe/wp-content/uploads/2019/06/La-Gobernanza-de-la-Minería.pdf (accessed on 2 June 2022).
- Adamek, K.; Lupa, M.; Zawadzki, M. for tracking changes caused by illegal gold mining in Madre de Dios, Peru. Misc. Geogr. 2021, 25, 205–212. [Google Scholar]
- Smith, N.M. “Our gold is dirty, but we want to improve”: Challenges to addressing mercury use in artisanal and small-scale gold mining in Peru. J. Clean. Prod. 2019, 222, 646–654. [Google Scholar] [CrossRef]
- Gunson, A.J.; Veiga, M.M. Mercury and artisanal mining in China. Environ. Pract. 2004, 6, 109–120. [Google Scholar] [CrossRef]
- Esdaile, L.J.; Chalker, J.M. The mercury problem in artisanal and small-scale gold mining. Chem.—A Eur. J. 2018, 24, 6905–6916. [Google Scholar] [CrossRef]
- Hilson, G.; Hilson, C.J.; Pardie, S. Improving awareness of mercury pollution in small-scale gold mining communities: Challenges and ways forward in rural Ghana. Environ. Res. 2007, 103, 275–287. [Google Scholar] [CrossRef]
- Davies, G.R. A toxic free future: Is there a role for alternatives to mercury in small-scale gold mining? Futures 2014, 62, 113–119. [Google Scholar] [CrossRef]
- Budnik, L.T.; Casteleyn, L. Mercury pollution in modern times and its socio-medical consequences. Sci. Total Environ. 2019, 654, 720–734. [Google Scholar] [CrossRef] [PubMed]
- Bernhoft, R.A. Mercury toxicity and treatment: A review of the literature. J. Environ. Public Health 2012, 2012, 460508. [Google Scholar] [CrossRef] [PubMed]
- Efectos en la Salud por la Exposición al Mercurio. Available online: https://espanol.epa.gov/espanol/efectos-en-la-salud-por-la-exposicion-al-mercurio (accessed on 10 July 2022).
- El Mercurio y la Salud. Available online: https://www.who.int/es/news-room/fact-sheets/detail/mercury-and-health#:~:text=El%20mercurio%20elemental%20y%20el,con%20consecuencias%20a%20veces%20fatales (accessed on 2 July 2022).
- Bhardwaj, V.; Nurchi, V.M.; Sahoo, S.K. Mercury toxicity and detection using chromo-fluorogenic chemosensors. Pharmaceuticals 2021, 14, 123. [Google Scholar] [CrossRef] [PubMed]
- Rustagi, N.; Singh, R. Mercury and health care. Indian J. Occup. Environ. Med. 2010, 14, 45. [Google Scholar]
- Methylmercury. Available online: https://www.greenfacts.org/es/mercurio/n-3/mercurio-2.htm#1p2 (accessed on 5 July 2022).
- Jackson, A.C. Chronic neurological disease due to methylmercury poisoning. Can. J. Neurol. Sci. 2018, 45, 620–623. [Google Scholar] [CrossRef] [PubMed]
- Manceau, A.; Bourdineaud, J.P.; Oliveira, R.B.; Sarrazin, S.L.; Krabbenhoft, D.P.; Eagles-Smith, C.A.; Ackerman, J.T.; Stewart, A.R.; Ward-Deitrich, C.; del Castillo Busto, M.E.; et al. Demethylation of methylmercury in bird, fish, and earthworm. Environ. Sci. Technol. 2021, 55, 1527–1534. [Google Scholar] [CrossRef] [PubMed]
- Ma, M.; Du, H.; Wang, D. Mercury methylation by anaerobic microorganisms: A review. Crit. Rev. Environ. Sci. Technol. 2019, 49, 1893–1936. [Google Scholar] [CrossRef]
- Lei, P.; Tang, C.; Wang, Y.; Wu, M.; Kwong, R.W.; Jiang, T.; Zhong, H. Understanding the effects of sulfur input on mercury methylation in rice paddy soils. Sci. Total Environ. 2021, 778, 146325. [Google Scholar] [CrossRef]
- Telmer, K.H.; Veiga, M.M. World emissions of mercury from artisanal and small scale gold mining. In Mercury Fate and Transport in the Global Atmosphere; Springer: Boston, MA, USA, 2009; pp. 131–172. [Google Scholar]
- Moody, K.H.; Hasan, K.M.; Aljic, S.; Blakeman, V.M.; Hicks, L.P.; Loving, D.C.; Moore, M.E.; Hammett, B.S.; Silva-González, M.; Seney, C.S.; et al. Mercury emissions from Peruvian gold shops: Potential ramifications for Minamata compliance in artisanal and small-scale gold mining communities. Environ. Res. 2020, 182, 109042. [Google Scholar] [CrossRef]
- UN Environment. Global Mercury Assessment 2018. UN Environment Programme, Chemicals and Health Branch. 2019. Available online: https://www.unep.org/resources/publication/global-mercury-assessment-2018 (accessed on 5 June 2022).
- Mercury-Free Mining: UNDP, GEF and the Government of Peru Work Together to Reduce the Use of Mercury in Artisanal and Small-Scale Gold Mining. Available online: https://www.thegef.org/newsroom/news/mercury-free-mining-undp-gef-and-government-peru-work-together-reduce-use-mercury (accessed on 19 July 2022).
- Wang, W.; Han, C.; Xie, F. Efficient mercury recovery from mercuric-thiosulfate solutions by ultraviolet photolysis. Environ. Chem. Lett. 2018, 16, 1049–1054. [Google Scholar] [CrossRef]
- Guney, M.; Akimzhanova, Z.; Kumisbek, A.; Beisova, K.; Kismelyeva, S.; Satayeva, A.; Inglezakis, V.; Karaca, F. Mercury (HG) contaminated sites in kazakhstan: Review of current cases and site remediation responses. Int. J. Environ. Res. Public Health 2020, 17, 8936. [Google Scholar] [CrossRef] [PubMed]
- Liu, Y.; Zhang, R.; Sun, Z.; Shen, Q.; Li, Y.; Wang, Y.; Xia, S.; Zhao, J.; Wang, X. Remediation of artificially contaminated soil and groundwater with copper using hydroxyapatite/calcium silicate hydrate recovered from phosphorus-rich wastewater. Environ. Pollut. 2021, 272, 115978. [Google Scholar] [CrossRef] [PubMed]
- Chibuike, G.U.; Obiora, S.C. Heavy metal polluted soils: Effect on plants and bioremediation methods. Appl. Environ. Soil Sci. 2014, 2014, 752708. [Google Scholar] [CrossRef]
- Chang, J.; Duan, Y.; Dong, J.; Shen, S.; Si, G.; He, F.; Yang, Q.; Chen, J. Bioremediation of Hg-contaminated soil by combining a novel Hg-volatilizing Lecythophora sp. fungus, DC-F1, with biochar: Performance and the response of soil fungal community. Sci. Total Environ. 2019, 671, 676–684. [Google Scholar] [CrossRef]
- Zhao, M.M.; Kou, J.B.; Chen, Y.P.; Xue, L.G.; Fan, T.T.; Wang, S.M. Bioremediation of wastewater containing mercury using three newly isolated bacterial strains. J. Clean. Prod. 2021, 299, 126869. [Google Scholar] [CrossRef]
- Chang, J.; Yang, Q.; Dong, J.; Ji, B.; Si, G.; He, F.; Li, B.; Chen, J. Reduction in Hg phytoavailability in soil using Hg-volatilizing bacteria and biochar and the response of the native bacterial community. Microb. Biotechnol. 2019, 12, 1014–1023. [Google Scholar] [CrossRef]
- Mahbub, K.R.; Bahar, M.M.; Labbate, M.; Krishnan, K.; Andrews, S.; Naidu, R.; Megharaj, M. Bioremediation of mercury: Not properly exploited in contaminated soils! Appl. Microbiol. Biotechnol. 2017, 101, 963–976. [Google Scholar] [CrossRef]
- Chen, S.; Lin, W.; Chien, C.; Tsang, D.C.; Kao, C. Development of a two-stage biotransformation system for mercury-contaminated soil remediation. Chemosphere 2018, 200, 266–273. [Google Scholar] [CrossRef]
- Fernandez-F, F.; Lopez-C, P.; Febres-Molina, C.; Gamero-Begazo, P.L.; Gómez, B.; Bernabe-Ortiz, J.C.; Cáceres-Huambo, A.; Aguilar-Pineda, J.A. Identification and Characterization of Peruvian Native Bacterial Strains as Bioremediation of Hg-Polluted Water and Soils Due to Artisanal and Small-Scale Gold Mining in the Secocha Annex, Arequipa. Sustainability 2022, 14, 2669. [Google Scholar] [CrossRef]
- Available online: https://cdn.www.gob.pe/uploads/document/file/2429209/msdoc.pdf (accessed on 6 May 2022).
- Arana, M.; Montoya, P. Reporte de Inventario: Estimaciones de Referencia del Uso y Consumo de Mercurio en la Minería de oro Artesanal y de Pequeña Escala en Perú. 2017. Available online: https://www.artisanalgold.org/wordpress/wp-content/uploads/2020/09/Reporte-de-inventario-MAPE_Peru.pdf (accessed on 11 June 2022).
- Arequipa: Piden Estado de Emergencia Para Secocha por Contaminación. Available online: https://elbuho.pe/2018/05/arequipa-piden-estado-de-emergencia-para-secocha-por-contaminacion/ (accessed on 2 May 2022).
- Huerta, A.; Lavado, W.; Atlas de Zonas Áridas del Perú: Una evaluación presente y futura. Servicio Nacional de Meteorología e Hidrología del Perú. 2021. Available online: https://repositorio.senamhi.gob.pe/handle/20.500.12542/1206 (accessed on 3 June 2022).
- Secocha, el Desolador Nuevo Paraje Arequipeño de la Minería Ilegal. Available online: https://energiminas.com/secocha-el-desolador-nuevo-paraje-arequipeno-de-la-mineria-ilegal/ (accessed on 3 May 2022).
- Decreto Supremo N° 011-2017-MINAM.-. Available online: https://www.minam.gob.pe/disposiciones/decreto-supremo-n-011-2017-minam/ (accessed on 23 August 2021).
- Stanchi, N.O.; Martino, P.E.; Gentilini, E.; Reinoso, E.; Echeverría, M.; Leardini, N.; Copes, J.A. Microbiología Veterinaria; Buenos Aires: Inter-Médica, Argentina, 2007. [Google Scholar]
- Fujimoto, S.; Nakagami, Y.; Kojima, F. Optimal bacterial DNA isolation method using bead-beating technique. Mem. Kyushu Univ Health Scis Med. Sch 2004, 3, 33–38. [Google Scholar]
- Zhang, Z.; Schwartz, S.; Wagner, L.; Miller, W. A greedy algorithm for aligning DNA sequences. J. Comput. Biol. 2000, 7, 203–214. [Google Scholar] [CrossRef] [PubMed]
- Tamura, K.; Stecher, G.; Kumar, S. MEGA11: Molecular evolutionary genetics analysis version 11. Mol. Biol. Evol. 2021, 38, 3022–3027. [Google Scholar] [CrossRef] [PubMed]
- Bauer, A. Antibiotic susceptibility testing by a standardized single disc method. Am. J. Clin. Pathol. 1966, 45, 149–158. [Google Scholar] [CrossRef]
- Igwe, J.; Abia, A. Adsorption kinetics and intraparticulate diffusivities for bioremediation of Co (II), Fe (II) and Cu (II) ions from waste water using modified and unmodified maize cob. Int. J. Phys. Sci. 2007, 2, 119–127. [Google Scholar]
- Chwastowski, J.; Staroń, P.; Kołoczek, H.; Banach, M. Adsorption of hexavalent chromium from aqueous solutions using Canadian peat and coconut fiber. J. Mol. Liq. 2017, 248, 981–989. [Google Scholar] [CrossRef]
- Kalpana, R.; Maheshwaran, M.; Vimali, E.; Soosai, M.R.; Shivamathi, C.S.; Moorthy, I.G.; Ashokkumar, B.; Varalakshmi, P. Decolorization of textile dye by halophilic Exiguobacterium sp. VK1: Biomass and exopolysaccharide (EPS) enhancement for bioremediation of Malachite Green. ChemistrySelect 2020, 5, 8787–8797. [Google Scholar] [CrossRef]
- Weber, W.J., Jr.; Morris, J.C. Kinetics of adsorption on carbon from solution. J. Sanit. Eng. Div. 1963, 89, 31–59. [Google Scholar] [CrossRef]
- Moré, J.J. The Levenberg-Marquardt algorithm: Implementation and theory. In Numerical Analysis; Springer: Berlin/Heidelberg, Germany, 1978; pp. 105–116. [Google Scholar]
- OriginLab Corporation. Origin(Pro), Version 2020*. Available online: https://www.originlab.com/2020 (accessed on 5 September 2021).
- Greenman, J.; Ieropoulos, I.A. Allometric scaling of microbial fuel cells and stacks: The lifeform case for scale-up. J. Power Sources 2017, 356, 365–370. [Google Scholar] [CrossRef]
- Rimskaya-Korsakova, N.; Fontaneto, D.; Galkin, S.; Malakhov, V.; Martínez, A. Geochemistry drives the allometric growth of the hydrothermal vent tubeworm Riftia pachyptila (Annelida: Siboglinidae). Zool. J. Linn. Soc. 2021, 193, 281–294. [Google Scholar] [CrossRef]
- Shadrack, R.S.; Manabu, I.; Yokoyama, S. Efficacy of single and mix probiotic bacteria strain on growth indices, physiological condition and bio-chemical composition of juvenile amberjack (Seriola dumerili). Aquac. Rep. 2021, 20, 100753. [Google Scholar] [CrossRef]
- IBM Corp. IBM SPSS Statistics for Windows. Available online: https://www.ibm.com/pe-es/products/spss-statistics?lnk=ushpv18ct7 (accessed on 10 August 2021).
- Rau, P.; Bourrel, L.; Labat, D.; Frappart, F.; Ruelland, D.; Lavado, W.; Dewitte, B.; Felipe, O. Hydroclimatic change disparity of Peruvian Pacific drainage catchments. Theor. Appl. Climatol. 2018, 134, 139–153. [Google Scholar] [CrossRef]
- Yukie, H.; Otto, S. Desertification: A Visual Synthesis; United Nations Convention to Combat Desertification: Paris, France, 2011; Volume 102, Available online: https://library.unccd.int/Details/fullCatalogue/10 (accessed on 5 May 2022).
- National Environment Protection Council. Schedule B(1) Guideline on the Investigation Levels for Soil and Groundwater, National Environment Protection (Assessment of Site Contamination) Measure. 2011. Available online: https://www.legislation.gov.au/Details/F2011L02093 (accessed on 6 May 2022).
- Cepa, C. Canadian Soil Quality Guidelines for the Protection of Environmental and Human Health; National Guidelines and Standards Office: Quebec, QC, Canada, 2007. [Google Scholar]
- Kocuria, sp. Strain RA10 16S ribosomal RNA Gene, Partial Sequence. Available online: https://www.ncbi.nlm.nih.gov/nucleotide/MN371311.1?report=genbank&log\protect\T1\textdollar=nucltop&blast_rank=4&RID=E8YY4ZB0016 (accessed on 4 May 2022).
- Uncultured Bacterium Clone LHSH2 16S ribosomal RNA Gene, Partial Sequence. Available online: https://www.ncbi.nlm.nih.gov/nuccore/MK910105.1/ (accessed on 4 May 2022).
- Sorescu, I.; Stoica, C. Online Advanced Bacterial Identification Software, an Original Tool for Phenotypic Bacterial Identification. Rom. Biotechnol. Lett. 2021, 26, 3047–3053. [Google Scholar] [CrossRef]
- Stackebrandt, E.; Koch, C.; Gvozdiak, O.; Schumann, P. Taxonomic Dissection of the Genus Micrococcus: Kocuria gen. nov., Nesterenkonia gen. nov., Kytococcus gen. nov., Dermacoccus gen. nov., and Micrococcus Cohn 1872 gen. emend. Int. J. Syst. Evol. Microbiol. 1995, 45, 682–692. [Google Scholar] [CrossRef] [PubMed]
- Karnwal, A.; Bhardwaj, V.; Dohroo, A.; Upadhyay, A.K.; Bala, R. Effect of microbial surfactants on heavy metal polluted wastewater. Pollut. Res. 2018, 37, 39–46. [Google Scholar]
- Karkouri, A.E.; Kaoutar, H.; Arroud, H.; Hassouni, M.E. Hexavalent chromium removal from a tannery effluent by a bacterial consortium. Moroc. J. Chem. 2019, 7, 4–7. [Google Scholar]
- François, F.; Lombard, C.; Guigner, J.M.; Soreau, P.; Brian-Jaisson, F.; Martino, G.; Vandervennet, M.; Garcia, D.; Molinier, A.L.; Pignol, D.; et al. Isolation and characterization of environmental bacteria capable of extracellular biosorption of mercury. Appl. Environ. Microbiol. 2012, 78, 1097–1106. [Google Scholar] [CrossRef]
- Velásquez-Riaño, M.; Benavides-Otaya, H.D. Bioremediation techniques applied to aqueous media contaminated with mercury. Crit. Rev. Biotechnol. 2016, 36, 1124–1130. [Google Scholar] [CrossRef]
- Gholami, M.; Etemadifar, Z.; Bouzari, M. Isolation a new strain of Kocuria rosea capable of tolerating extreme conditions. J. Environ. Radioact. 2015, 144, 113–119. [Google Scholar] [CrossRef]
- Zhihengliuella alba Strain DQ70 16S ribosomal RNA Gene, Partial Sequence. Available online: https://www.ncbi.nlm.nih.gov/nucleotide/KU147427.1?report=genbank&log\protect\T1\textdollar=nucltop&blast_rank=1&RID=98K6KHS4016 (accessed on 1 April 2022).
- Hamada, M.; Shibata, C.; Tamura, T.; Suzuki, K.i. Zhihengliuella flava sp. nov., an actinobacterium isolated from sea sediment, and emended description of the genus Zhihengliuella. Int. J. Syst. Evol. Microbiol. 2013, 63, 4760–4764. [Google Scholar] [CrossRef]
- Tang, S.K.; Wang, Y.; Chen, Y.; Lou, K.; Cao, L.L.; Xu, L.H.; Li, W.J. Zhihengliuella alba sp. nov., and emended description of the genus Zhihengliuella. Int. J. Syst. Evol. Microbiol. 2009, 59, 2025–2032. [Google Scholar] [CrossRef]
- Zhang, Y.Q.; Schumann, P.; Yu, L.Y.; Liu, H.Y.; Zhang, Y.Q.; Xu, L.H.; Stackebrandt, E.; Jiang, C.L.; Li, W.J. Zhihengliuella halotolerans gen. nov., sp. nov., a novel member of the family Micrococcaceae. Int. J. Syst. Evol. Microbiol. 2007, 57, 1018–1023. [Google Scholar] [CrossRef] [PubMed]
- Mishra, A.; Gupta, B.; Kumar, N.; Singh, R.; Varma, A.; Thakur, I.S. Synthesis of calcite-based bio-composite biochar for enhanced biosorption and detoxification of chromium Cr (VI) by Zhihengliuella sp. ISTPL4. Bioresour. Technol. 2020, 307, 123262. [Google Scholar] [CrossRef] [PubMed]
- Gupta, B.; Mishra, A.; Singh, R.; Thakur, I.S. Fabrication of calcite based biocomposites for catalytic removal of heavy metals from electroplating industrial effluent. Environ. Technol. Innov. 2021, 21, 101278. [Google Scholar] [CrossRef]
- Mishra, A.; Rathour, R.; Singh, R.; Kumari, T.; Thakur, I.S. Degradation and detoxification of phenanthrene by actinobacterium Zhihengliuella sp. ISTPL4. Environ. Sci. Pollut. Res. 2020, 27, 27256–27267. [Google Scholar] [CrossRef] [PubMed]
- Igiri, B.E.; Okoduwa, S.I.; Idoko, G.O.; Akabuogu, E.P.; Adeyi, A.O.; Ejiogu, I.K. Toxicity and bioremediation of heavy metals contaminated ecosystem from tannery wastewater: A review. J. Toxicol. 2018, 2018, 2568038. [Google Scholar] [CrossRef] [PubMed]
- Von Canstein, H.; Li, Y.; Leonhäuser, J.; Haase, E.; Felske, A.; Deckwer, W.D.; Wagner-Döbler, I. Spatially oscillating activity and microbial succession of mercury-reducing biofilms in a technical-scale bioremediation system. Appl. Environ. Microbiol. 2002, 68, 1938–1946. [Google Scholar] [CrossRef] [PubMed]
- Restrepo, J.F.P. Guía para el uso de antibióticos en cirugia; Fundación OFA para el Avance de las Ciencias Biomédicas: Bogotá, Colombia, 1986. [Google Scholar]
- Antimicrobial Wild Type Distributions of Microorganisms. Available online: https://mic.eucast.org/search/?search%5Bmethod%5D=diff&search%5Bantibiotic%5D=2&search%5Bspecies%5D=-1&search%5Bdisk_content%5D=-1&search%5Blimit%5D=50 (accessed on 9 May 2022).
- Saranya, K.; Sundaramanickam, A.; Shekhar, S.; Swaminathan, S.; Balasubramanian, T. Bioremediation of mercury by Vibrio fluvialis screened from industrial effluents. BioMed Res. Int. 2017, 2017, 6509648. [Google Scholar] [CrossRef]
- Abbas, S.; Rafatullah, M.; Hossain, K.; Ismail, N.; Tajarudin, H.; Abdul Khalil, H. A review on mechanism and future perspectives of cadmium-resistant bacteria. Int. J. Environ. Sci. Technol. 2018, 15, 243–262. [Google Scholar] [CrossRef]
- Naguib, M.M.; Khairalla, A.S.; El-Gendy, A.O.; Elkhatib, W.F. Isolation and characterization of mercury-resistant bacteria from wastewater sources in Egypt. Can. J. Microbiol. 2019, 65, 308–321. [Google Scholar] [CrossRef]
- Kandi, V.; Palange, P.; Vaish, R.; Bhatti, A.B.; Kale, V.; Kandi, M.R.; Bhoomagiri, M.R. Emerging bacterial infection: Identification and clinical significance of Kocuria species. Cureus 2016, 8, e731. [Google Scholar] [CrossRef]
- Valencia, V.C.; de La Cruz, C.O.; Bixano, O.A.; Ruíz, M.K.H.; Estrada, E.E.S. Infecciones asociadas a Kocuria kristinae: Presentación de dos casos y revisión de la literatura. Gaceta Médica de México 2014, 150, 183–185. [Google Scholar]
- Agudelo, G.A.C.; Arango, I.V.; Villamil, G.E.R.; Rincón, C.I.G.; Ríos, J.G.T.; Correa, J.C.C.; Vega, F.R.; Vélez, V.P. Infección diseminada por Kocuria spp.: Reporte de caso y revisión de la literatura. Enfermedades Infecc. Microbiol. 2021, 41, 39–44. [Google Scholar]
- Jha, B.; Singh, V.K.; Weiss, A.; Hartmann, A.; Schmid, M. Zhihengliuella somnathii sp. nov., a halotolerant actinobacterium from the rhizosphere of a halophyte Salicornia brachiata. Int. J. Syst. Evol. Microbiol. 2015, 65, 3137–3142. [Google Scholar] [CrossRef] [PubMed]
- Baik, K.S.; Lim, C.H.; Park, S.C.; Choe, H.N.; Kim, H.J.; Kim, D.; Lee, K.H.; Seong, C.N. Zhihengliuella aestuarii sp. nov., isolated from tidal flat sediment. Int. J. Syst. Evol. Microbiol. 2011, 61, 1671–1676. [Google Scholar] [CrossRef][Green Version]
- Puicon, Y.; Hurtado, J.E. Bioremediacion de Suelos Contaminados con Mercurio Utilizando Pseudomonas sp. Aisladas de Zonas de Mineria Informal; Universidad Peruana Cayetano Heredia: Lima, Perú, 2019; pp. 1–7. [Google Scholar]
- Sánchez Dávila, J.; Hurtado Custodio, J. Mercury reduction by bacteria isolated from informal mining zones. Adv. Mater. Res. Trans. Tech. Publ. 2009, 71, 637–640. [Google Scholar] [CrossRef]
- Ismadji, S.; Soetaredjo, F.E.; Ayucitra, A. The kinetic studies in the adsorption of hazardous substances using clay minerals. In Clay Materials for Environmental Remediation; Springer: Cham, Switzerland, 2015; pp. 113–120. [Google Scholar]
- Olson, P.E.; Wong, T.; Leigh, M.B.; Fletcher, J.S. Allometric modeling of plant root growth and its application in rhizosphere remediation of soil contaminants. Environ. Sci. Technol. 2003, 37, 638–643. [Google Scholar] [CrossRef]
- Ciadamidaro, L.; Girardclos, O.; Bert, V.; Zappelini, C.; Yung, L.; Foulon, J.; Papin, A.; Roy, S.; Blaudez, D.; Chalot, M. Poplar biomass production at phytomanagement sites is significantly enhanced by mycorrhizal inoculation. Environ. Exp. Bot. 2017, 139, 48–56. [Google Scholar] [CrossRef]
- Liu, J.; Jia, X.; Wen, J.; Zhou, Z. Substrate interactions and kinetics study of phenolic compounds biodegradation by Pseudomonas sp. cbp1-3. Biochem. Eng. J. 2012, 67, 156–166. [Google Scholar] [CrossRef]

| Soil Type | ECA | SQG, Canada | HIL, Australia | Secocha |
|---|---|---|---|---|
| Peru | CCME 2002 | NEPM 2013 | Annex | |
| Agricultural | 6.0 | 6.6 | 12.0 | |
| Residential, Park | 6.0 | 6.6 | 400.0 | 7.7 |
| Commercial, Industrial, Extractive | 24.0 | 24.0 (50.0) | 4000.0 | 49.0 |
| Antibiotic | QPD | Inhibition Zone | Measure | Category | |
|---|---|---|---|---|---|
| R | S | Diameter | |||
| Ciprofloxacin (CIP) | 5 µg | 15.0 | 21.0 | 23.0 | Sensitive (2) |
| 13.0 | Resistant | ||||
| Lincomycin (MY15) | 2 µg | 16.0 | 21.0 | 0.0 | Resistant |
| 18.0 | Intermediate | ||||
| Azithromycin (AZM) | 15 µg | 13.0 | 18.0 | 16.0 | Intermediate |
| 11.0 | Resistant | ||||
| Amikacin (AN30) | 30 µg | 14.0 | 17.0 | 12.0 | Resistant |
| 12.0 | Resistant | ||||
| Amoxicillin (AML10) | 25 µg | 11.0 | 14.0 | 0.0 | Resistant |
| 18.0 | Sensitive (4) | ||||
| Levofloxacin (LEV) | 5 µg | 13.0 | 17.0 | 22.0 | Sensitive (5) |
| 17.0 | Sensitive (0) | ||||
| Enrofloxacin (ENR5) | 5 µg | 16.0 | 23.0 | 25.0 | Sensitive (2) |
| 18.0 | Intermediate | ||||
| Amoxicillin + | 30 µg | 13.0 | 18.0 | 0.0 | Resistant |
| Clavulanic ac. (AMC30) | 20.0 | Sensitive (2) | |||
| Description | Total | Query | Percent | Accession | Accession |
|---|---|---|---|---|---|
| Score | Cover | Identity | Length | ||
| T1.1 strain | |||||
| Kocuria sp. strain L14 | 1694 | 100 | 99.35 | 1408 | MT516480.1 |
| Kocuria rosea strain QT-159 | 1694 | 100 | 99.35 | 1437 | MT081097.1 |
| Kocuria sp. strain XHTSA5 | 1694 | 100 | 99.35 | 1399 | MK033457.1 |
| Kocuria sp. strain RA10 | 1694 | 100 | 99.35 | 1078 | MN371311.1 |
| Kocuria sp. strain TBZ229 | 1694 | 100 | 99.35 | 1398 | MN227531.1 |
| Uncultured bacterium clone LHSH2 | 1694 | 100 | 99.35 | 1435 | MK910105.1 |
| Kocuria rosea strain c11 | 1694 | 100 | 99.35 | 1401 | MK696235.1 |
| Kocuria sp. strain T3186-4 | 1694 | 100 | 99.35 | 1185 | MG254794.1 |
| Kocuria rosea strain HBUM03354 | 1694 | 100 | 99.35 | 1450 | MF662260.1 |
| Kocuria sp. strain TBZ225 | 1694 | 100 | 99.35 | 1414 | MH410524.1 |
| T3 strain | |||||
| Z. a. strain DQ70 | 1664 | 99 | 99.78 | 1409 | KU147427.1 |
| Z. a. gene | 1664 | 99 | 99.78 | 1484 | AB778263.1 |
| Z. a. strain YIM 90734 | 1664 | 99 | 99.78 | 1454 | NR_044575.1 |
| Z. a. strain B1kh77 | 1663 | 100 | 99.67 | 1379 | MK737182.1 |
| Z. a. strain J0f78 | 1661 | 100 | 99.67 | 1366 | MK737136.1 |
| Z. sp. strain 20-Secocha-AQP | 1661 | 100 | 99.67 | 930 | ON307471.1 |
| Z. sp. strain TN-Gafsa-I5-P27f-1392r-20091105 | 1661 | 100 | 99.67 | 1289 | GU451719.1 |
| Z. a. strain 150SS-7 | 1633 | 100 | 98.90 | 1443 | MK016483.1 |
| Z. a. strain 210-LR22 | 1631 | 99 | 99.12 | 1437 | MF077154.1 |
| Z. a. strain B4b42 | 1628 | 97 | 99.77 | 1344 | MK737333.1 |
| Time (h) | Experimental Values | Weber–Morris Model | Allometric Model | ||||||
|---|---|---|---|---|---|---|---|---|---|
| q | % ads. | Rate | q | % ads. | Rate | q | % ads. | Rate | |
| T1.1 strain | |||||||||
| 0 | 0.00 | 0.00 | - | 0.00 | 0.00 | - | 0.00 | 0.00 | - |
| 12 | 9.00 | 5.56 | 0.75 | 4.89 | 3.02 | 0.41 | 8.35 | 5.15 | 0.70 |
| 24 | 12.00 | 7.41 | 0.25 | 6.91 | 4.27 | 0.17 | 10.79 | 6.66 | 0.20 |
| 48 | 13.00 | 8.02 | 0.04 | 9.78 | 6.04 | 0.12 | 13.96 | 8.62 | 0.13 |
| 720 | 36.00 | 22.22 | 0.03 | 37.86 | 23.37 | 0.04 | 38.11 | 23.53 | 0.04 |
| 1080 | 46.00 | 28.40 | 0.03 | 46.37 | 28.62 | 0.02 | 44.30 | 27.35 | 0.02 |
| T3 strain | |||||||||
| 0 | 0.00 | 0.00 | - | 0.00 | 0.00 | - | 0.00 | 0.00 | - |
| 12 | 3.00 | 1.85 | 0.25 | 6.10 | 3.77 | 0.51 | 8.55 | 5.28 | 0.71 |
| 24 | 9.00 | 5.56 | 0.50 | 8.62 | 5.32 | 0.21 | 11.44 | 7.06 | 0.24 |
| 48 | 21.00 | 12.96 | 0.50 | 12.19 | 7.52 | 0.15 | 15.29 | 9.44 | 0.16 |
| 720 | 50.00 | 30.66 | 0.04 | 47.23 | 29.15 | 0.05 | 47.52 | 29.33 | 0.05 |
| 1080 | 54.00 | 33.33 | 0.01 | 57.84 | 35.70 | 0.03 | 56.31 | 34.76 | 0.02 |
Publisher’s Note: MDPI stays neutral with regard to jurisdictional claims in published maps and institutional affiliations. |
© 2022 by the authors. Licensee MDPI, Basel, Switzerland. This article is an open access article distributed under the terms and conditions of the Creative Commons Attribution (CC BY) license (https://creativecommons.org/licenses/by/4.0/).
Share and Cite
López-Casaperalta, P.; Febres-Molina, C.; Aguilar-Pineda, J.A.; Bernabe-Ortiz, J.C.; Fernandez-F, F. Peruvian Native Bacterial Strains as Potential Bioremediation Agents in Hg-Polluted Soils by Artisanal Mining Activities in Southern Peru. Sustainability 2022, 14, 10272. https://doi.org/10.3390/su141610272
López-Casaperalta P, Febres-Molina C, Aguilar-Pineda JA, Bernabe-Ortiz JC, Fernandez-F F. Peruvian Native Bacterial Strains as Potential Bioremediation Agents in Hg-Polluted Soils by Artisanal Mining Activities in Southern Peru. Sustainability. 2022; 14(16):10272. https://doi.org/10.3390/su141610272
Chicago/Turabian StyleLópez-Casaperalta, Patricia, Camilo Febres-Molina, Jorge Alberto Aguilar-Pineda, Julio Cesar Bernabe-Ortiz, and Fernando Fernandez-F. 2022. "Peruvian Native Bacterial Strains as Potential Bioremediation Agents in Hg-Polluted Soils by Artisanal Mining Activities in Southern Peru" Sustainability 14, no. 16: 10272. https://doi.org/10.3390/su141610272
APA StyleLópez-Casaperalta, P., Febres-Molina, C., Aguilar-Pineda, J. A., Bernabe-Ortiz, J. C., & Fernandez-F, F. (2022). Peruvian Native Bacterial Strains as Potential Bioremediation Agents in Hg-Polluted Soils by Artisanal Mining Activities in Southern Peru. Sustainability, 14(16), 10272. https://doi.org/10.3390/su141610272






